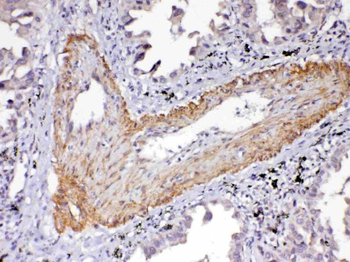
VEGF Receptor 2/KDR Antibody

You have no items in your shopping cart.
Description
Research Area
Images & Validation
−| Application Notes |
|---|
Key Properties
−| Source | E.coli |
|---|---|
| Biological Origin | Homo sapiens (Human) |
| Tag | N-terminal GST-tagged |
| Expression Region | 20-764aa |
| Protein Length | Extracellular Domain |
| MW | 110.3 kDa |
| Purity | Greater than 90% as determined by SDS-PAGE. |
| Protein Sequence | ASVGLPSVSLDLPRLSIQKDILTIKANTTLQITCRGQRDLDWLWPNNQSGSEQRVEVTECSDGLFCKTLTIPKVIGNDTGAYKCFYRETDLASVIYVYVQDYRSPFIASVSDQHGVVYITENKNKTVVIPCLGSISNLNVSLCARYPEKRFVPDGNRISWDSKKGFTIPSYMISYAGMVFCEAKINDESYQSIMYIVVVVGYRIYDVVLSPSHGIELSVGEKLVLNCTARTELNVGIDFNWEYPSSKHQHKKLVNRDLKTQSGSEMKKFLSTLTIDGVTRSDQGLYTCAASSGLMTKKNSTFVRVHEKPFVAFGSGMESLVEATVGERVRIPAKYLGYPPPEIKWYKNGIPLESNHTIKAGHVLTIMEVSERDTGNYTVILTNPISKEKQSHVVSLVVYVPPQIGEKSLISPVDSYQYGTTQTLTCTVYAIPPPHHIHWYWQLEEECANEPSQAVSVTNPYPCEEWRSVEDFQGGNKIEVNKNQFALIEGKNKTVSTLVIQAANVSALYKCEAVNKVGRGERVISFHVTRGPEITLQPDMQPTEQESVSLWCTADRSTFENLTWYKLGPQPLPIHVGELPTPVCKNLDTLWKLNATMFSNSTNDILIMELKNASLQDQGDYVCLAQDRKTKKRHCVVRQLTVLERVAPTITGNLENQTTSIGESIEVSCTASGNPPPQIMWFKDNETLVEDSGIVLKDGNRNLTIRRVRKEDEGLYTCQACSVLGCAKVEAFFIIEGAQEKTNLE |
Storage & Handling
−| Storage | The shelf life is related to many factors, storage state, buffer ingredients, storage temperature and the stability of the protein itself. Generally, the shelf life of liquid form is 6 months at -20℃/-80℃. The shelf life of lyophilized form is 12 months at -20℃/-80℃. |
|---|---|
| Form/Appearance | Liquid or Lyophilized powder |
| Buffer/Preservatives | If the delivery form is liquid, the default storage buffer is Tris/PBS-based buffer, 5%-50% glycerol. If the delivery form is lyophilized powder, the buffer before lyophilization is Tris/PBS-based buffer, 6% Trehalose, pH 8.0. |
| Expiration Date | 6 months from date of receipt. |
| Disclaimer | For research use only |
Alternative Names
−Similar Products
−VEGFR2 Rabbit Polyclonal Antibody [orb11557]
ELISA, ICC, IF, IHC-P, WB
Canine, Human, Mouse, Porcine, Rat
Rabbit
Polyclonal
Unconjugated
100 μgVEGF Receptor 2/KDR Rabbit Polyclonal Antibody [orb402416]
FC, ICC, IHC, WB
Human
Rabbit
Polyclonal
Unconjugated
100 μgRecombinant Mouse VEGFR2 Protein [orb2993886]
Unconjugated
SDS-PAGE: Greater than 95% as determined by reducing SDS-PAGE.
Predicted: 110 KDa. Observed: 140-170 KDa, reducing conditions
10 μg, 50 μg, 500 μg, 1 mgRecombinant Human VEGFR2 Protein (Biotin) [orb2993796]
Biotin
SDS-PAGE: Greater than 95% as determined by reducing SDS-PAGE.
Predicted: 86.1 KDa. Observed: 120-150 KDa, reducing conditions
100 μg, 20 μgRecombinant Human VEGFR2 Protein [orb2994764]
Unconjugated
SDS-PAGE: Greater than 95% as determined by reducing SDS-PAGE.
Predicted: 84.3 KDa. Observed: 110-140 KDa, reducing conditions
10 μg, 50 μg, 500 μg, 1 mg

Quality Guarantee
Explore bioreagents carefree to elevate your research. All our products are rigorously tested for performance. If a product does not perform as described on its datasheet, our scientific support team will provide expert troubleshooting, a prompt replacement, or a refund. For full details, please see our Terms & Conditions and Buying Guide. Contact us at [email protected].

(Tris-Glycine gel) Discontinuous SDS-PAGE (reduced) with 5% enrichment gel and 15% separation gel.
Quick Database Links
UniProt Details
−Documents Download
Request a Document
Protocol Information
Human VEGFR2 protein (orb244321)
Participating in our Biorbyt product reviews program enables you to support fellow scientists by sharing your firsthand experience with our products.
Login to Submit a Review